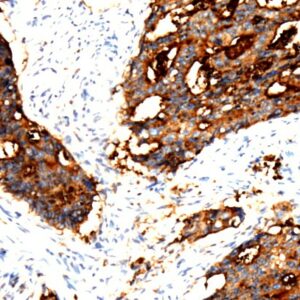
Anti-CEACAM1

International
Showing 281–300 of 329 resultsSorted by latest
-

Hsa-miR-22 Probe
Read more -

HsamiR21 Probe
Price range: $269.00 through $715.00 Select options This product has multiple variants. The options may be chosen on the product page -

HsamiR20A Probe
Read more -

HsamiR19a
Read more -

HsamiR18a
Price range: $295.00 through $715.00 Select options This product has multiple variants. The options may be chosen on the product page -

HsamiR17 Probe
Read more -

HsamiR15B Probe
Read more -

HsamiR15a Probe
Read more -

HsamiR10b Probe
Read more -

Hsa-miR-9
Read more -

Hsa-miR-let-7g Probe
Read more -

Hsa-miR-7e
Read more -

Hsa-miR-let-7d Probe
Read more -

Hsa-miR-Let-7c
Read more -

HsamiRlet7b Probe
Read more -

HsamiR7a Probe
Read more -

HsamiR1 Probe
Read more -
Anti-CEACAM1
Read more -

Anti-Toxoplasma gondii
Read more -

Anti-Herpes Simplex Virus Type II (HSV II)
Read more

